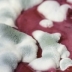

Мир →
Трамп оправдался, что он не пророссийский, а просто переживает за РФ
Президент подчеркнул, что в России "очень мощная" армия, однако гораздо более слабая экономика
18 Июля
Президент подчеркнул, что в России "очень мощная" армия, однако гораздо более слабая экономика
18 Июля

Мир →
Встреча Путина Трампа: все подробности, видео и конфузы
Лидеры двух стран общались более четырех часов
16 Июля
Лидеры двух стран общались более четырех часов
16 Июля

Мир →
Переговоры Путина и Трампа с глазу на глаз затянулись
Первоначально они должны были длиться не более 90 минут
16 Июля
Первоначально они должны были длиться не более 90 минут
16 Июля

Мир →
На пляже в Румынии пьяный водитель въехал в группу туристов
Авария произошла из-за несоблюдения скоростного режима на опасном участке дороги
16 Июля
Авария произошла из-за несоблюдения скоростного режима на опасном участке дороги
16 Июля

Мир →
В США на производителей детской присыпки подали в суд
Обвинитель утверждает, что продукт вызывает рак
16 Июля
Обвинитель утверждает, что продукт вызывает рак
16 Июля

Мир →
Трамп дал Мэй жесткий совет по Brexit
Великобритания должна судиться с ЕС, а не вести переговоры, считает американский президент
15 Июля
Великобритания должна судиться с ЕС, а не вести переговоры, считает американский президент
15 Июля
Мир →
Маккейн о встрече Трампа и Путина: Либо отказаться, либо говорить с позиции силы
Сенатор дал Трампу важные советы перед разговором с Путиным
15 Июля
Сенатор дал Трампу важные советы перед разговором с Путиным
15 Июля

Мир →
Смертельная жара в Японии: шесть человек погибли, более полутора тысяч пострадали
В некоторых районах страны температура достигала до 39 градусов Цельсия
14 Июля
В некоторых районах страны температура достигала до 39 градусов Цельсия
14 Июля

Мир →
В Лондоне десятки тысяч человек вышли на антитрамповский протест
Антитрамповская акция объединила людей разных убеждений: противников и сторонников Brexit, профсоюзы, женские организации и правозащитников
14 Июля
Антитрамповская акция объединила людей разных убеждений: противников и сторонников Brexit, профсоюзы, женские организации и правозащитников
14 Июля


Мир →
Великобритания представила новый план "мягкого" Brexit
Документ уже сравнили с соглашением об ассоциации между Украиной и Евросоюзом
12 Июля
Документ уже сравнили с соглашением об ассоциации между Украиной и Евросоюзом
12 Июля

Мир →
В США арестовали порноактрису, которая "встречалась" с Трампом
Сторми Дэниэлс была арестована в Колумбусе, штат Огайо, за шоу, с которым она выступала по всей стране в сотне стриптиз-клубов
12 Июля
Сторми Дэниэлс была арестована в Колумбусе, штат Огайо, за шоу, с которым она выступала по всей стране в сотне стриптиз-клубов
12 Июля

Мир →
Трамп предложил союзникам в два раза увеличить финансирование НАТО
Вклад США в бюджет НАТО в прошлом году составлял около 3,57% от ВВП страны
12 Июля
Вклад США в бюджет НАТО в прошлом году составлял около 3,57% от ВВП страны
12 Июля
Мир →
В российском кафе посетителей накормили продуктами пятилетней давности
Просроченные продукты использовали в кафе "Мечта"
12 Июля
Просроченные продукты использовали в кафе "Мечта"
12 Июля

Мир →
В Италии пройдет забастовка из-за перехода Криштиану Роналду в "Ювентус"
Сотрудники завода возмущены нерациональной тратой денег
11 Июля
Сотрудники завода возмущены нерациональной тратой денег
11 Июля
Реклама
|
|


 Следующие 15 новостей
Следующие 15 новостей 